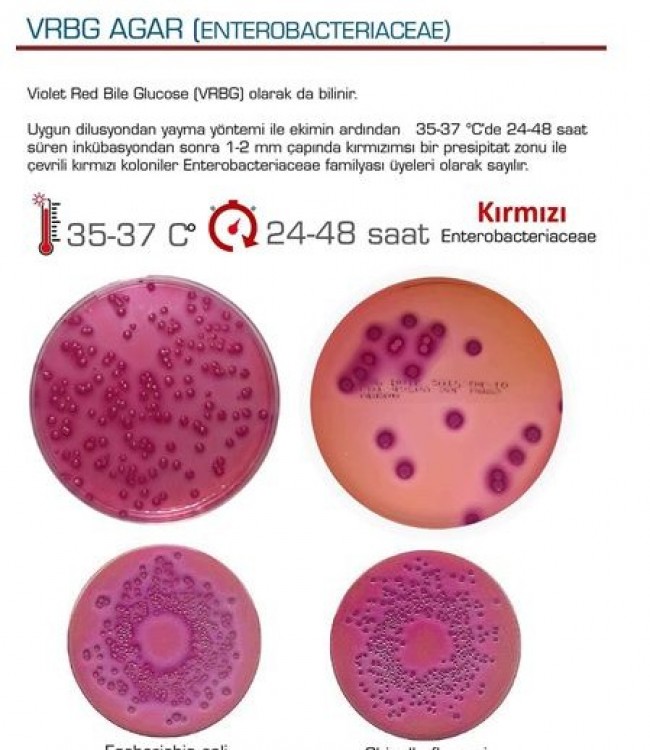

VRB Agar (Violet Red Bile Agar)
VRB AGAR (VİOLET RED BILE AGAR)
Uygun dilusyondan yayma yöntemi ile ekimin ardından 35-37C 24-48 saat süren
inkübasyondan sonra 1-2 mm çapında kırmızımsı bir presipitat zonu ile çevrili kırmızı koloniler, Enterobaoteriaoeae familyasının laktoz pozitif üyeleri olan koliform grup bakteriler olarak sayılır.
FEKAL COLIFORM TESPİTİ
Fekal coliform grubu mikroorganizma analizinde VRB Agar kullanılır.
İnkübasyon derecesi normal koliform grup mikroorganizma analizinden farklı
olarak 44,5 C'de 24—48 saattir.
Bu sıcaklıkta üreyen tipik koloniler sayılarak sonuç verilir.